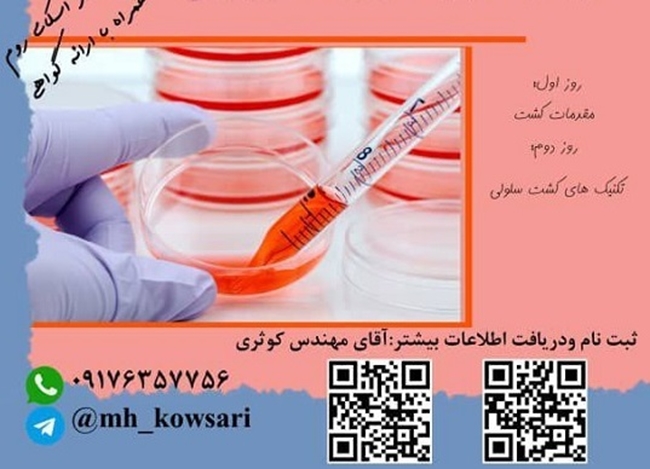
02.jpg

روابط عمومی معاونت تحقیقات و فناوری دانشگاه؛
برگزاری وبینار آموزشی کشت سلولی
وبینار آموزشی کشت سلولی طی دو روز در مورخ: 29 و 30 خرداد ماه 1401 از ساعت 17 الی 19 با تدریس دکتر زهرا مطلوبی دکترای ایمونولوژی پزشکی برگزار خواهد شد.


نظر دهید